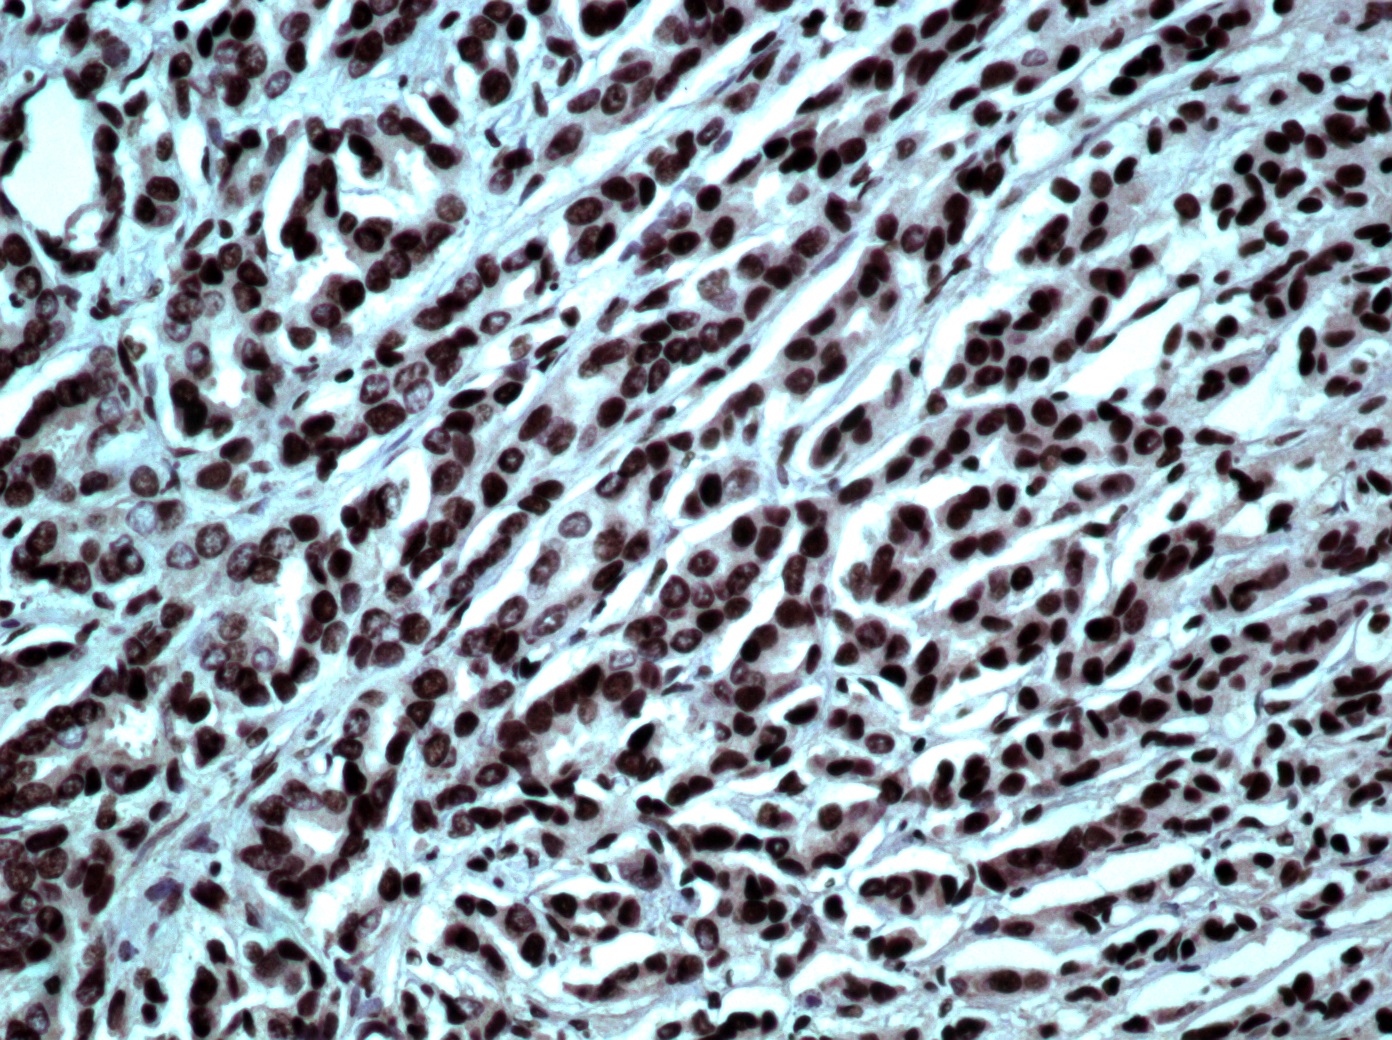
Hsa-miR-331-3p Probe

Hsa-miR-331-3p Probe
The fluoresceinated Hsa-miR-331-3p probe has been designed from mature human miR-331-3p sequence. This Hsa-miR-331-3p identifies miR-331-3p sequences in formalin-fixed, paraffin-embedded human tissues and freshly prepared frozen tissues by in situ hybridization. This probe does not react with normal human mRNA or nuclear DNA present in tissues.
| Intended Use | ASR |
|---|---|
| Control tissue | Heart |
| Pack | 0.650 ml, 5 control slides |